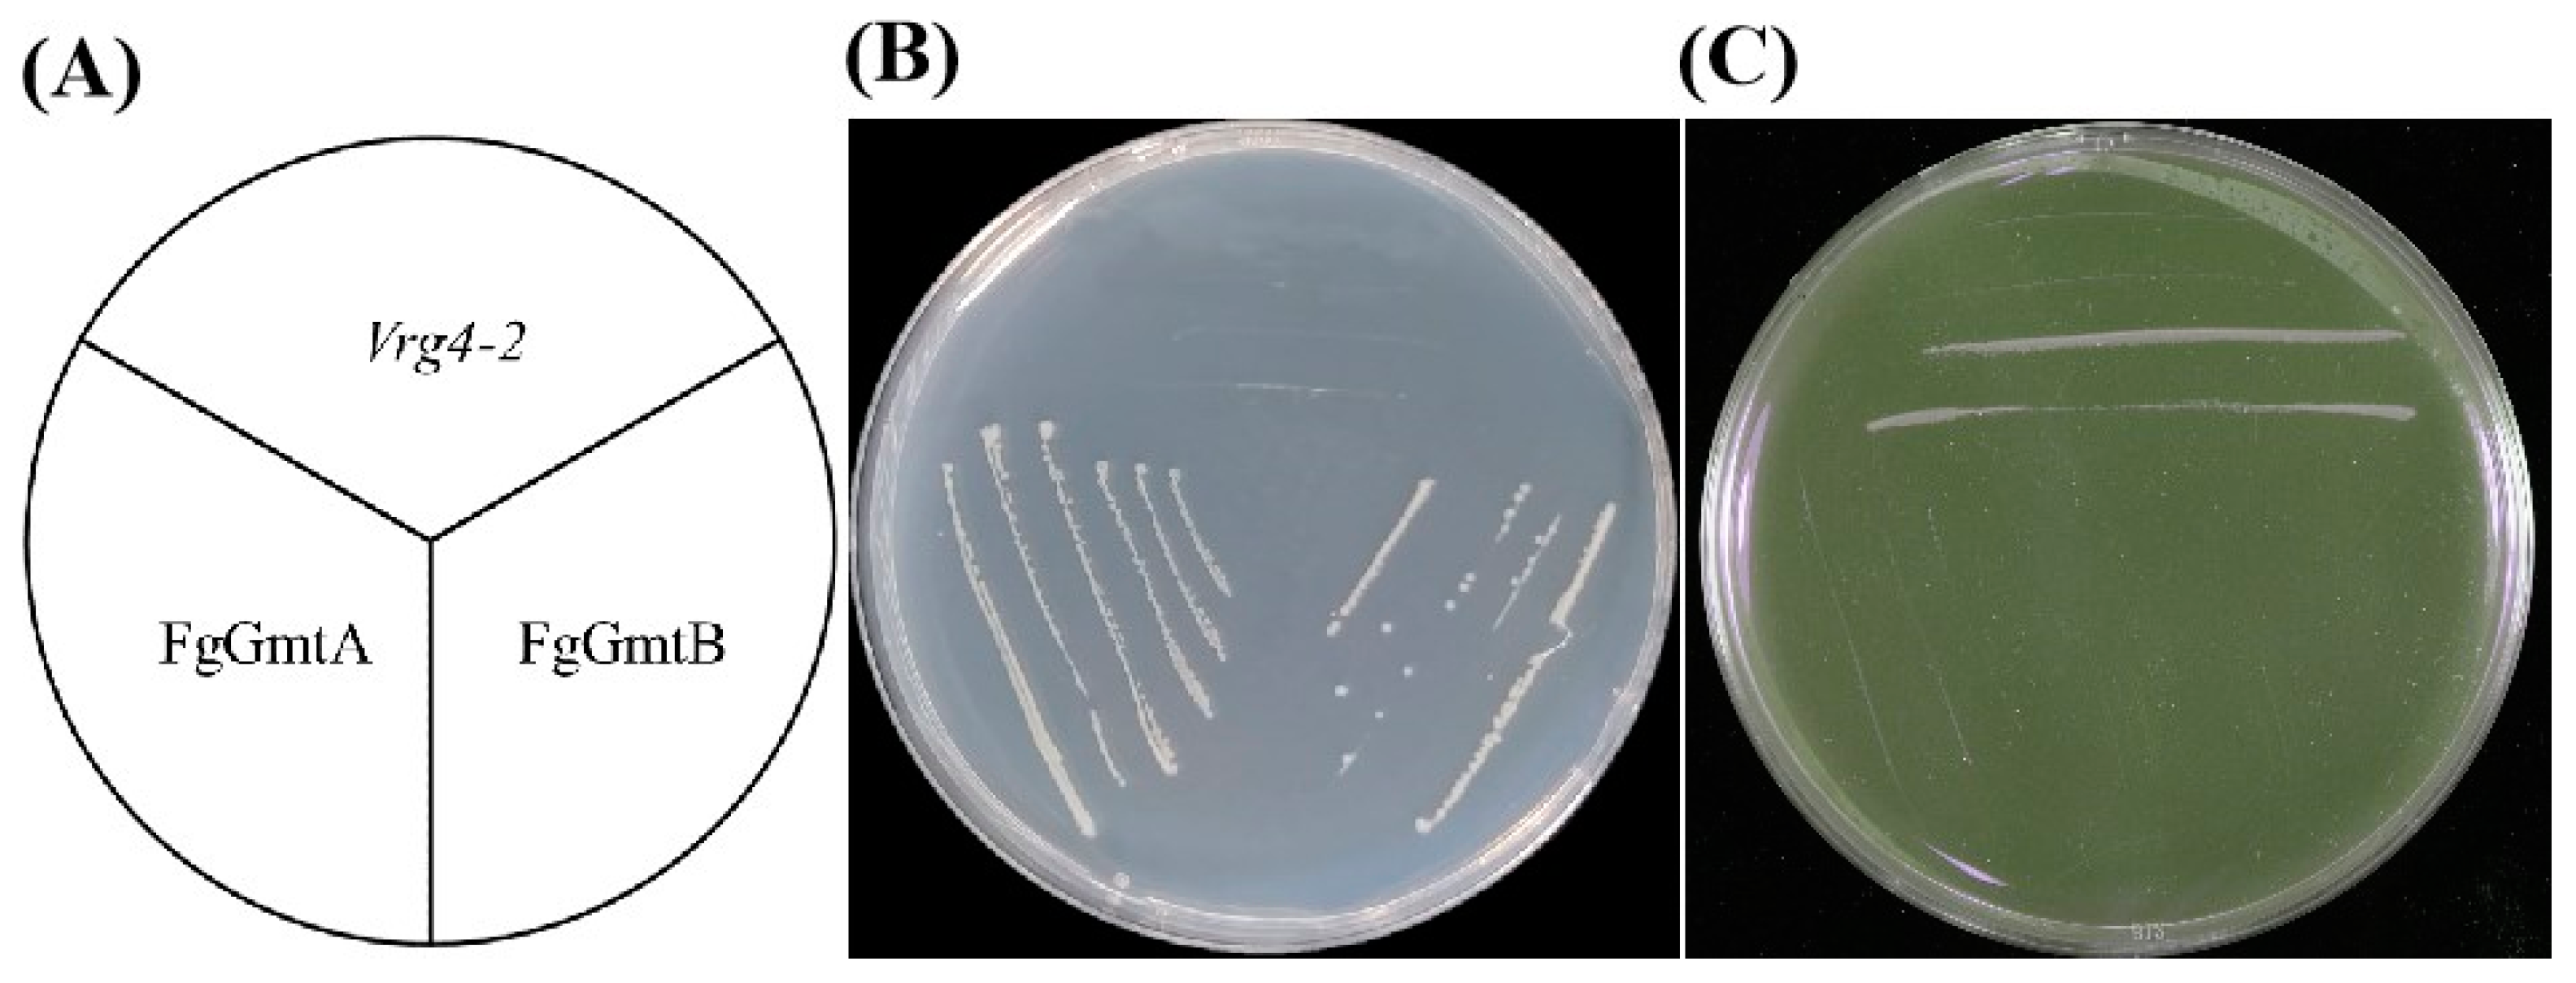
Jof 10 00208 g002 Jof 10 00208 g002
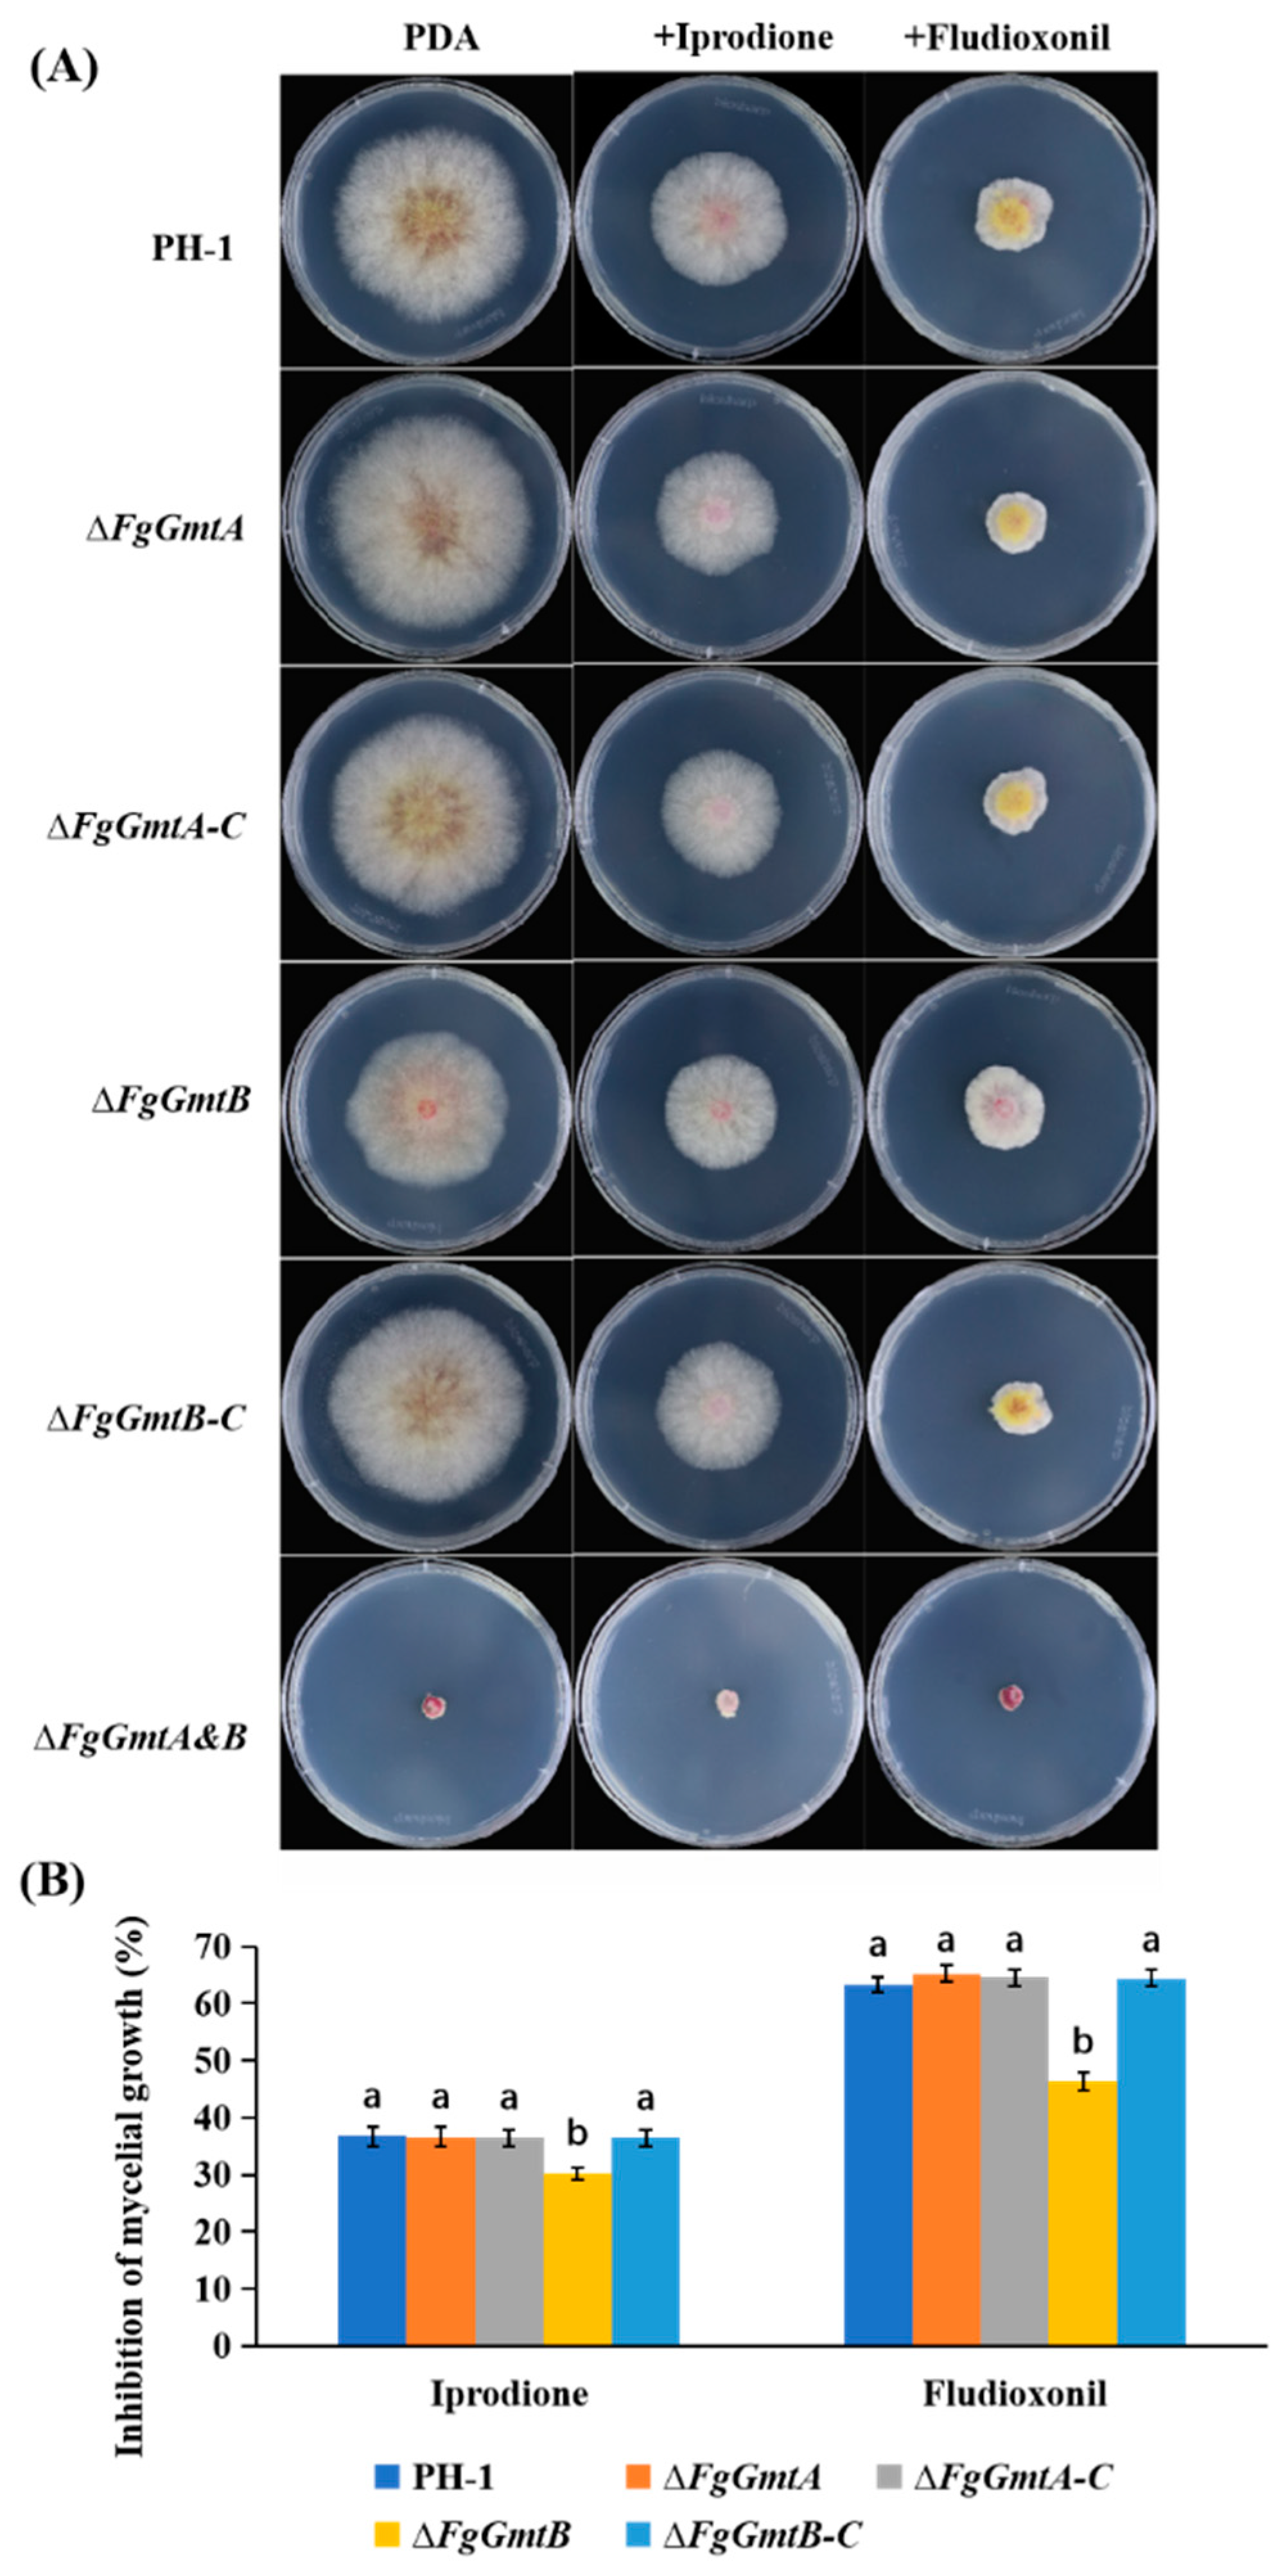
Jof 10 00208 g009 Jof 10 00208 g009

FgGmtB Plays an Important Role in Growth, Reproduction, Virulence and Deoxynivalenol Biosynthesis of Fusarium graminearum
Abstract
1. Introduction
2. Materials and Methods
2.1. Strains and Plants
2.2. Phylogenetic Tree Construction, Sequence Alignment and Conserved Motif/Domain Analysis of FgGmts
2.3. Gene Knockout and Complementation by Protoplast Transformation
2.4. Determination of the Utilisation of Different Carbon Sources
2.5. Asexual and Sexual Reproduction Assays
2.6. The F. graminearum Pathogenicity Test
2.7. Determination of Deoxynivalenol (DON) Toxin in F. graminearum
2.8. Sensitivity of Mycelial Growth to Cell Wall Disruptor Multiple Stress Detection
2.9. Determination of Fungal Susceptibility to Fungicides
2.10. Statistical Analysis
3. Results
3.1. Sequence Alignment and Phylogenetic Analysis of FgGmts Proteins from Different Organisms
3.2. Function of FgGmtA and FgGmtB in F. graminearum with S. cerevisiae VRG4 Can Complement Each Other
3.3. FgGmts Knockout and Complementation in F. graminearum
3.4. FgGmtB Is Involved in the Regulation of Mannose Utilisation
3.5. FgGmtB Is Involved in Hyphal Growth in F. graminearum
3.6. FgGmtB Is Important for Asexual Reproduction
3.7. FgGmtB Is Important for Sexual Reproduction
3.8. FgGmtB Is Involved in the Regulation of Pathogenicity of F. graminearum
3.9. FgGmtB Affects DON Biosynthesis and the Expression of TRI Gene in F. graminearum
3.10. FgGmtB Is Involved in the Regulation of Cell Wall Integrity in F. graminearum
3.11. FgGmtB Is Involved in the Regulation of Osmotic Stress and Glycerol Synthesis in F. graminearum
3.12. FgGmtB Is Involved in Regulating the Sensitivity of F. graminearum to Fungicides
4. Discussion
5. Conclusions
Supplementary Materials
Author Contributions
Funding
Institutional Review Board Statement
Informed Consent Statement
Data Availability Statement
Acknowledgments
Conflicts of Interest
References
- Shi, D.Y.; Ren, W.C.; Wang, J.; Zhang, J.; Jane Ifunanya, M.; Mao, X.W.; Chen, C.J. The transcription factor FgNsf1 regulates fungal development, virulence and stress responses in Fusarium graminearum. J. Integr. Agric. 2021, 20, 14. [Google Scholar] [CrossRef]
- Lofgren, L.A.; Leblanc, N.R.; Certano, A.K.; Nachtigall, J.; Labine, K.M.; Riddle, J.; Broz, K.; Dong, Y.; Bethan, B.; Kafer, C.W. Fusarium graminearum: Pathogen or endophyte of North American grasses? New Phytol. 2018, 217, 1203–1212. [Google Scholar] [CrossRef] [PubMed]
- Cortinovis, C.; Pizzo, F.; Spicer, L.J.; Caloni, F. Fusarium mycotoxins: Effects on reproductive function in domestic animals—A review. Theriogenology 2013, 80, 557–564. [Google Scholar] [CrossRef]
- Palazzini, J.M.; Torres, A.M.; Chulze, S.N. Tolerance of triazole-based fungicides by biocontrol agents used to control Fusarium head blight in wheat in Argentina. Lett. Appl. Microbiol. 2018, 66, 434–438. [Google Scholar] [CrossRef]
- Cromey, M.; Lauren, D.; Parkes, R.; Sinclair, K.; Shorter, S.; Wallace, A. Control of Fusarium head blight of wheat with fungicides. Australas. Plant Pathol. 2001, 30, 301–308. [Google Scholar] [CrossRef]
- Willyerd, K.T.; Li, C.; Madden, L.V.; Bradley, C.A.; Bergstrom, G.C.; Sweets, L.E.; McMullen, M.; Ransom, J.K.; Grybauskas, A.; Osborne, L. Efficacy and stability of integrating fungicide and cultivar resistance to manage Fusarium head blight and deoxynivalenol in wheat. Plant Dis. 2012, 96, 957–967. [Google Scholar] [CrossRef]
- Ákos, M.; Beáta, T.; Monika, V.; Tibor, B.; Ágnes, S.H.; László, F.; Szabolcs, L.K. Role of fungicides, application of nozzle types, and the resistance level of wheat varieties in the control of Fusarium head blight and deoxynivalenol. Toxins 2011, 3, 1453–1483. [Google Scholar] [CrossRef]
- Nishikawa, A.; Poster, J.B.; Jigami, Y.; Dean, N. Molecular and phenotypic analysis of CaVRG4, encoding an essential Golgi apparatus GDP-mannose transporter. J. Bacteriol. 2002, 184, 29–42. [Google Scholar] [CrossRef] [PubMed]
- Nishikawa, A.; Mendez, B.; Jigami, Y.; Dean, N. Identification of a Candida glabrata homologue of the S. cerevisiae VRG4 gene, encoding the Golgi GDP-mannose transporter. Yeast 2002, 19, 691–698. [Google Scholar] [CrossRef]
- Baldwin, T.C.; Handford, M.G.; Yuseff, M.I.; Orellana, A.; Dupree, P. Identification and characterization of GONST1, a Golgi-localized GDP-mannose transporter in Arabidopsis. Plant Cell 2001, 13, 2283–2295. [Google Scholar] [CrossRef]
- Handford, M.G.; Sicilia, F.; Brandizzi, F.; Chung, J.H.; Dupree, P. Arabidopsis thaliana expresses multiple Golgi-localised nucleotide-sugar transporters related to GONST1. Mol. Genet. Genom. 2004, 272, 397–410. [Google Scholar] [CrossRef]
- Gao, X.D.; Nishikawa, A.; Dean, N. Identification of a conserved motif in the yeast Golgi GDP-mannose transporter required for binding to nucleotide sugar. J. Biol. Chem. 2001, 276, 4424–4432. [Google Scholar] [CrossRef]
- Dean, N.; Zhang, Y.B.; Poster, J.B. The VRG4 gene is required for GDP-mannose transport into the lumen of the Golgi in the yeast, Saccharomyces cerevisiae. J. Biol. Chem. 1997, 272, 31908–31914. [Google Scholar] [CrossRef]
- Abeijon, C.; Mandon, E.C.; Hirschberg, C.B. Transporters of nucleotide sugars, nucleotide sulfate and ATP in the Golgi apparatus. Trends Biochem. Sci. 1997, 22, 203–207. [Google Scholar] [CrossRef]
- Forestier, C.L.; Gao, Q.; Boons, G.J. Leishmania lipophosphoglycan: How to establish structure-activity relationships for this highly complex and multifunctional glycoconjugate? Front. Cell. Infect. Microbiol. 2015, 4, 193. [Google Scholar] [CrossRef]
- Latgé, J.P.; Mouyna, I.; Tekaia, F.; Beauvais, A.; Debeaupuis, J.P.; Nierman, W. Specific molecular features in the organization and biosynthesis of the cell wall of Aspergillus fumigatus. Med. Mycol. 2005, 43, 15–22. [Google Scholar] [CrossRef] [PubMed]
- Gastebois, A.; Clavaud, C.; Aimanianda, V.; Latgé, J.P. Aspergillus fumigatus: Cell wall polysaccharides, their biosynthesis and organization. Future Microbiol. 2009, 4, 583–595. [Google Scholar] [CrossRef] [PubMed]
- Jin, C. Protein glycosylation in Aspergillus fumigatus is essential for cell wall synthesis and serves as a promising model of multicellular eukaryotic development. Int. J. Microbiol. 2012, 2012, 654251. [Google Scholar] [CrossRef] [PubMed]
- D’Angelo, D.L.; Bradley, C.A.; Ames, K.A.; Willyerd, K.T.; Madden, L.V.; Paul, P.A. Efficacy of fungicide applications during and after anthesis against Fusarium head blight and deoxynivalenol in soft red winter wheat. Plant Dis. 2014, 98, 1387–1397. [Google Scholar] [CrossRef] [PubMed]
- Engel, J.; Schmalhorst, P.S.; Routier, F.H. Biosynthesis of the fungal cell wall polysaccharide galactomannan requires intraluminal GDP-mannose. J. Biol. Chem. 2012, 287, 44418–44424. [Google Scholar] [CrossRef] [PubMed]
- Latgé, J.P. Tasting the fungal cell wall. Cell. Microbiol. 2010, 12, 863–872. [Google Scholar] [CrossRef] [PubMed]
- Jackson Hayes, L.; Hill, T.W.; Loprete, D.M.; Fay, L.M.; Gordon, B.S.; Nkashama, S.A.; Patel, R.K.; Sartain, C.V. Two GDP-mannose transporters contribute to hyphal form and cell wall integrity in Aspergillus nidulans. Microbiology 2008, 154, 2037–2047. [Google Scholar] [CrossRef]
- Kadry, A.A.; El-Ganiny, A.M.; Mosbah, R.A.; Kaminskyj, S.G.W. Deletion of Aspergillus nidulans GDP-mannose transporters affects hyphal morphometry, cell wall architecture, spore surface character, cell adhesion, and biofilm formation. Med. Mycol. 2018, 56, 621–630. [Google Scholar] [CrossRef] [PubMed]
- Jiang, H.; Ouyang, H.; Zhou, H.; Jin, C. GDP-mannose pyrophosphorylase is essential for cell wall integrity, morphogenesis and viability of Aspergillus fumigatus. Microbiology 2008, 154, 2730–2739. [Google Scholar] [CrossRef]
- Figueroa, M.; Hammond-Kosack, K.E.; Solomon, P.S. A review of wheat diseases—A field perspective. Mol. Plant Pathol. 2018, 19, 1523–1536. [Google Scholar] [CrossRef] [PubMed]
- Zheng, W.H.; Zhao, X.; Xie, Q.R.; Huang, Q.P.; Zhang, C.K.; Zhai, H.C.; Xu, L.P.; Lu, G.D.; Shim, W.B.; Wang, Z.H. A conserved homeobox transcription factor Htf1 is required for phialide development and conidiogenesis in Fusarium species. PLoS ONE 2012, 7, e45432. [Google Scholar] [CrossRef] [PubMed]
- Son, H.Y.; Kim, M.G.; Chae, S.K.; Lee, Y.W. FgFlbD regulates hyphal differentiation required for sexual and asexual reproduction in the ascomycete fungus Fusarium graminearum. J. Microbiol. 2014, 52, 930–939. [Google Scholar] [CrossRef]
- Son, H.Y.; Kim, M.G.; Min, K.H.; Seo, Y.S.; Lim, J.Y.; Choi, G.J.; Kim, J.C.; Chae, S.K.; Lee, Y.W. AbaA regulates conidiogenesis in the ascomycete fungus Fusarium graminearum. PLoS ONE 2013, 8, e72915. [Google Scholar] [CrossRef]
- Zheng, Q. The MAT Locms Genes Play Different Roles in Sexual Reproduction and Pathogenesis in Fusarium graminearum. Master’s Thesis, Northwest A&F University, Xianyang, China, 2015. [Google Scholar]
- Xu, X.M.; Nicholson, P. Community ecology of fungal pathogens causing wheat head blight. Annu. Rev. Phytopathol. 2009, 47, 83–103. [Google Scholar] [CrossRef]
- Hou, R. Function Characterization of AREA Gene in Fusarium graminearum. Ph.D. Thesis, Northwest A&F University, Xianyang, China, 2015. [Google Scholar]
- Yu, F.W.; Gu, Q.; Yun, Y.Z.; Yin, Y.N.; Xu, J.R.; Shim, W.B.; Ma, Z.H. The TOR signaling pathway regulates vegetative development and virulence in Fusarium graminearum. New Phytol. 2014, 203, 219–232. [Google Scholar] [CrossRef]
- Chayakulkeeree, M.; Sorrell, T.C.; Siafakas, A.R.; Wilson, C.F.; Pantarat, N.; Gerik, K.J.; Boadle, R.; Djordjevic, J.T. Role and mechanism of phosphatidylinositol-specific phospholipase C in survival and virulence of Cryptococcus neoformans. Mol. Microbiol. 2008, 69, 809–826. [Google Scholar] [CrossRef]
- Ding, M.Y.; Zhu, Q.L.; Liang, Y.S.; Li, J.; Fan, X.Y.; Yu, X.Y.; He, F.; Xu, H.J.; Liang, Y.C.; Yu, J.F. Differential roles of three FgPLD genes in regulating development and pathogenicity in Fusarium graminearum. Fungal Genet. Biol. 2017, 109, 46–52. [Google Scholar] [CrossRef]
- Zhu, Q.L.; Sun, L.; Lian, J.J.; Gao, X.L.; Zhao, L.; Ding, M.Y.; Li, J.; Liang, Y.C. The phospholipase C (FgPLC1) is involved in regulation of development, pathogenicity, and stress responses in Fusarium graminearum. Fungal Genet. Biol. 2016, 97, 1–9. [Google Scholar] [CrossRef] [PubMed]
- Xu, L.N.; Wang, H.K.; Zhang, C.Q.; Wang, J.L.; Chen, A.H.; Chen, Y.; Ma, Z.H. System-wide characterization of subtilases reveals that subtilisin-like protease FgPrb1 of Fusarium graminearum regulates fungal development and virulence. Fungal Genet. Biol. 2020, 144, 103449. [Google Scholar] [CrossRef] [PubMed]
- Yun, Y.Z.; Liu, Z.Y.; Zhang, J.Z.; Shim, W.B.; Chen, Y.; Ma, Z.H. The MAPKK FgMkk1 of Fusarium graminearum regulates vegetative differentiation, multiple stress response, and virulence via the cell wall integrity and high-osmolarity glycerol signaling pathways. Environ. Microbiol. 2014, 16, 2023–2037. [Google Scholar] [CrossRef] [PubMed]
- Zheng, D.w.; Zhang, S.j.; Zhou, X.y.; Wang, C.f.; Xiang, P.; Zheng, Q.; Xu, J.R. The FgHOG1 pathway regulates hyphal growth, stress responses, and plant infection in Fusarium graminearum. PLoS ONE 2012, 7, e49495. [Google Scholar] [CrossRef]
- Wojda, I.; Alonso-Monge, R.; Bebelman, J.-P.; Mager, W.H.; Siderius, M. Response to high osmotic conditions and elevated temperature in Saccharomyces cerevisiae is controlled by intracellular glycerol and involves coordinate activity of MAP kinase pathways. Microbiology 2003, 149, 1193–1204. [Google Scholar] [CrossRef]
- Gul, A.; Siddique, A.; Syed, Q.; Nadeem, M.; Baig, S. Osmotic stress response of Saccharomyces cerevisiae under HG and elevated temperature environment. Int. J. Environ. Monit. Anal. 2015, 3, 233–237. [Google Scholar] [CrossRef][Green Version]
- Leroux, P.; Lanen, C.; Fritz, R. Similarities in the antifungal activities of fenpiclonil, iprodione and tolclofos-methyl against Botrytis cinerea and Fusarium nivale. Pestic. Sci. 1992, 36, 255–261. [Google Scholar] [CrossRef]
- Noriyuki, O.; Takeshi, T.; Takumi, N.; Naoko, T.A.; Makoto, F.; Makoto, K. Involvement of the osmosensor histidine kinase and osmotic stress-activated protein kinases in the regulation of secondary metabolism in Fusarium graminearum. Biochem. Biophys. Res. Commun. 2007, 363, 639–644. [Google Scholar] [CrossRef]
- Zhang, Y.; Lamm, R.; Pillonel, C.; Lam, S.; Xu, J.R. Osmoregulation and fungicide resistance: The Neurospora crassa os-2 gene encodes a HOG1 mitogen-activated protein kinase homologue. Appl. Environ. Microbiol. 2002, 68, 532–538. [Google Scholar] [CrossRef] [PubMed]
- Noriyuki, O.; Makoto, F.; Takayuki, M.; Akihiko, I.; Ron, U.; Koki, H.; Isamu, Y. Characterization of mutations in the two-component histidine kinase gene that confer fludioxonil resistance and osmotic sensitivity in the os-1 mutants of Neurospora crassa. Pest Manag. Sci. Former. Pestic. Sci. 2001, 57, 437–442. [Google Scholar] [CrossRef]
- Abe, M.; Hashimoto, H.; Yoda, K. Molecular characterization of Vig4/Vrg4 GDP-mannose transporter of the yeast Saccharomyces cerevisiae. FEBS Lett. 1999, 458, 309–312. [Google Scholar] [CrossRef] [PubMed]
- Trail, F. For blighted waves of grain: Fusarium graminearum in the postgenomics era. Plant Physiol. 2009, 149, 103–110. [Google Scholar] [CrossRef] [PubMed]
- Trail, F.; Xu, H.; Loranger, R.; Gadoury, D. Physiological and environmental aspects of ascospore discharge in Gibberella zeae (anamorph Fusarium graminearum). Mycologia 2002, 94, 181–189. [Google Scholar] [CrossRef] [PubMed]
- Gao, X.L.; Zhang, J.; Song, C.N.; Yuan, K.Y.; Wang, J.H.; Jin, Q.J.; Xu, J.R. Phosphorylation by Prp4 kinase releases the self-inhibition of FgPrp31 in Fusarium graminearum. Curr. Genet. 2018, 64, 1261–1274. [Google Scholar] [CrossRef] [PubMed]
- Sun, M.L.; Bian, Z.Y.; Luan, Q.Q.; Chen, Y.T.; Wang, W.; Dong, Y.R.; Chen, L.F.; Hao, C.F.; Xu, J.R.; Liu, H.Q. Stage-specific regulation of purine metabolism during infectious growth and sexual reproduction in Fusarium graminearum. New Phytol. 2021, 230, 757–773. [Google Scholar] [CrossRef]
- Wang, C.Y.; Wang, Y.; Zhang, L.Y.; Yin, Z.Y.; Liang, Y.C.; Chen, L.; Zou, S.S.; Dong, H.S. The golgin protein RUD3 regulates Fusarium graminearum growth and virulence. Appl. Environ. Microbiol. 2021, 87, e02522-20. [Google Scholar] [CrossRef]
- Yu, Z.M.; He, C.M.; da Silva, J.A.T.; Luo, J.P.; Yang, Z.Y.; Duan, J. The GDP-mannose transporter gene (DoGMT) from Dendrobium officinale is critical for mannan biosynthesis in plant growth and development. Plant Sci. 2018, 277, 43–54. [Google Scholar] [CrossRef]
- Sairam, R.K.; Rao, K.V.; Srivastava, G.C. Differential response of wheat genotypes to long term salinity stress in relation to oxidative stress, antioxidant activity and osmolyte concentration. Plant Sci. 2002, 163, 1037–1046. [Google Scholar] [CrossRef]
- Ren, J.Y.; Li, C.L.; Gao, C.Y.; Xu, J.R.; Jiang, C.; Wang, G.H. Deletion of FgHOG1 is suppressive to the mgv1 mutant by stimulating Gpmk1 activation and avoiding intracellular turgor elevation in Fusarium graminearum. Front. Microbiol. 2019, 10, 1073. [Google Scholar] [CrossRef] [PubMed]
- Oshima, M.; Fujimura, M.; Banno, S.; Hashimoto, C.; Motoyama, T.; Ichiishi, A.; Yamaguchi, I. A point mutation in the two-component histidine kinase BcOS-1 gene confers dicarboximide resistance in field isolates of Botrytis cinerea. Phytopathology 2002, 92, 75–80. [Google Scholar] [CrossRef] [PubMed]

| Strain | Conidiation (105 Conidia/mL) | Germination (%) |
|---|---|---|
| PH-1 | 9.01 ± 0.25 b | 93.78 ± 0.09 b |
| ΔfgGmtA | 8.92 ± 0.17 b | 92.34 ± 0.12 b |
| ΔFgGmtB | 12.67 ± 0.52 a | 95.26 ± 0.05 a |
| ΔfgGmtA&B | 8.5 ± 0.39 b | 90.54 ± 0.07 c |
Disclaimer/Publisher’s Note: The statements, opinions and data contained in all publications are solely those of the individual author(s) and contributor(s) and not of MDPI and/or the editor(s). MDPI and/or the editor(s) disclaim responsibility for any injury to people or property resulting from any ideas, methods, instructions or products referred to in the content. |
© 2024 by the authors. Licensee MDPI, Basel, Switzerland. This article is an open access article distributed under the terms and conditions of the Creative Commons Attribution (CC BY) license (https://creativecommons.org/licenses/by/4.0/).
Share and Cite
Zhao, C.; Yang, X.; Jiang, W.; Zhang, G.; Ma, D. FgGmtB Plays an Important Role in Growth, Reproduction, Virulence and Deoxynivalenol Biosynthesis of Fusarium graminearum. J. Fungi 2024, 10, 208. https://doi.org/10.3390/jof10030208
Zhao C, Yang X, Jiang W, Zhang G, Ma D. FgGmtB Plays an Important Role in Growth, Reproduction, Virulence and Deoxynivalenol Biosynthesis of Fusarium graminearum. Journal of Fungi. 2024; 10(3):208. https://doi.org/10.3390/jof10030208
Chicago/Turabian StyleZhao, Chenming, Xiaoyue Yang, Wenqiang Jiang, Guifen Zhang, and Dongfang Ma. 2024. "FgGmtB Plays an Important Role in Growth, Reproduction, Virulence and Deoxynivalenol Biosynthesis of Fusarium graminearum" Journal of Fungi 10, no. 3: 208. https://doi.org/10.3390/jof10030208
APA StyleZhao, C., Yang, X., Jiang, W., Zhang, G., & Ma, D. (2024). FgGmtB Plays an Important Role in Growth, Reproduction, Virulence and Deoxynivalenol Biosynthesis of Fusarium graminearum. Journal of Fungi, 10(3), 208. https://doi.org/10.3390/jof10030208
